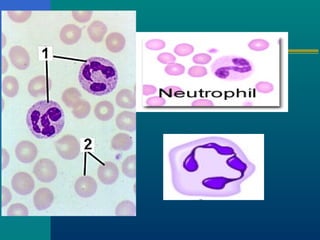

This document provides information about the blood and lymphatic system. It discusses how blood is composed of plasma and formed elements such as red blood cells, white blood cells and platelets. It also describes the functions of blood such as transporting oxygen, nutrients, hormones and waste products around the body. Additionally, the document discusses blood groups and the ABO and rhesus blood typing systems which determine transfusion compatibility.